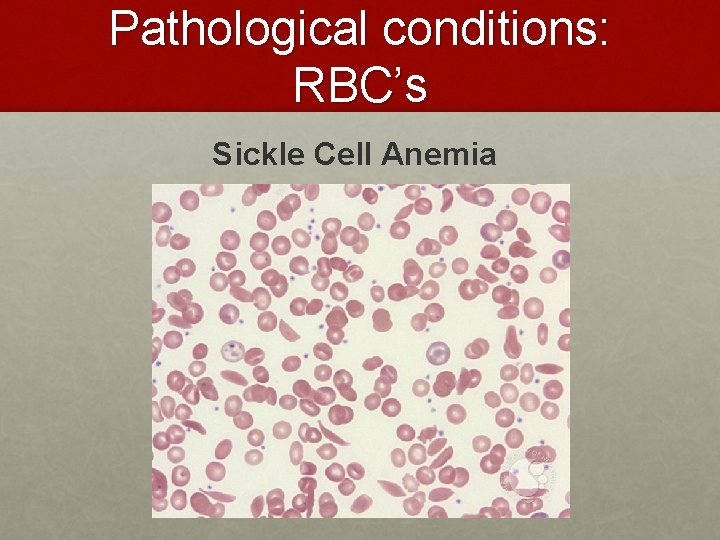
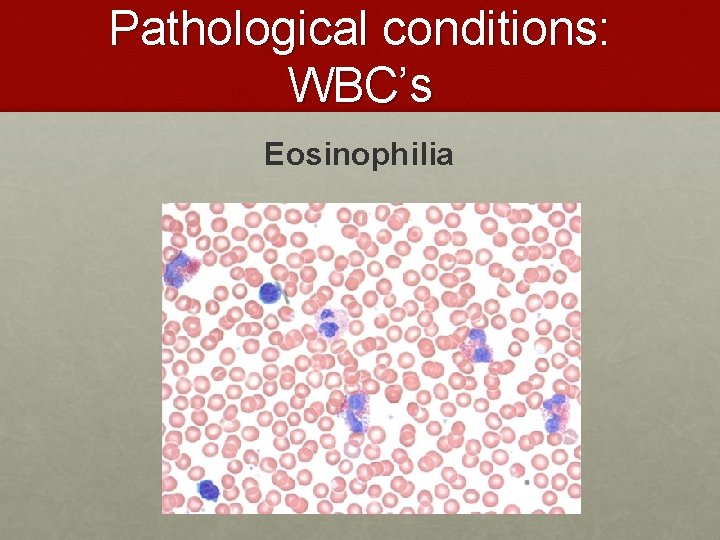

Human blood Structure and Function Biochemical and cellular

Human blood – Structure and Function Biochemical and cellular aspects of blood.

Blood • Structure • Connective tissue with cells suspended in liquid extracellular matrix (plasma) • Functions • Transport gases (O 2, CO 2), nutrients, hormones, waste • Distributes heat • Maintains homeostasis

Blood – Connective Tissue • Connective tissue = cells + fluid matrix • Blood = fluid matrix for movement

Blood Composition Ø Plasma = H 2 O + chemicals (vitamins, electrolytes, marcromolecules, gases) = 55% Ø Formed Elements = cells and platelets = 45%

Blood Components. Formed Elements Ø Red blood cells = erythrocytes = cells, no nucleus when mature Ø White blood cells = leukocytes = cells, with nucleus Ø Platelets = thromobcytes = not cells, small chunks of cell Ø ALL formed in bone marrow. Production stimulated by hormones RBC, platelet, WBC

Red Blood Cells • Formed in bone marrow • No nucleus when mature (only in mammals) • Limited life span • Transport O 2 and CO 2 • Hemoglobin = red colored protein that O 2 binds to • Also called Erythrocytes Red Blood Cell White Blood Cell

platelets • Not cells, cytoplasmic fragments of a large cell • Produce protein (fibrin) when activated with clotting factors • Fibrin traps RBC’s to produce a blood clot video

Blood and the immune response Ø The immune response is carried out by white blood cells (leukocytes) that leave the blood stream Ø When leukocytes leave the blood stream they are ‘fighting’ as part of an active immune response

Types of leukocytes

Types of leukocytes trigger blood vessel dilation by producing antibodies

Types of leukocytes Granulocytes Neutrophil video Eosinophil video Basophil What functions do these perform in the immune response?

Types of leukocytes Agranulocytes Lymphocyte video Monocyte What functions do these perform in the immune response?

Types of leukocytes

Types of leukocytes
Pathological conditions: RBC’s Sickle Cell Anemia

Pathological conditions: RBC’s Anemia

Differential WBC Count • Detection of changes in numbers of circulating WBCs • Indicates infection, poisoning, leukemia, chemotherapy, parasites or allergy reaction Normal WBC counts neutrophils 60 -70% (up if bacterial infection) lymphocyte 20 -25% (up if viral infection) monocytes 3 -- 8 % (up if fungal/viral infection) eosinophil 2 -- 4 % (up if parasite or allergy reaction) basophil <1% (up if allergy reaction or hypothyroid)

Pathological conditions: WBC’s

Pathological conditions: WBC’s Infectious Mononucleosis
Pathological conditions: WBC’s Eosinophilia

Complete Blood Cell Counts Using a hematocytometer

Complete Blood Cell Counts Using a hematocytometer

Complete Blood Cell Counts Using a hematocytometer The grid has specified dimensions so that the area covered by the lines is known, which makes it possible to count the number of cells in a specific volume of solution.

Complete Blood Cell Counts Using a hematocytometer

Complete Blood Cell Counts Using a hematocytometer

Complete Blood Cell Counts Using a hematocytometer

Complete Blood Cell Counts Using a hematocytometer
- Slides: 27